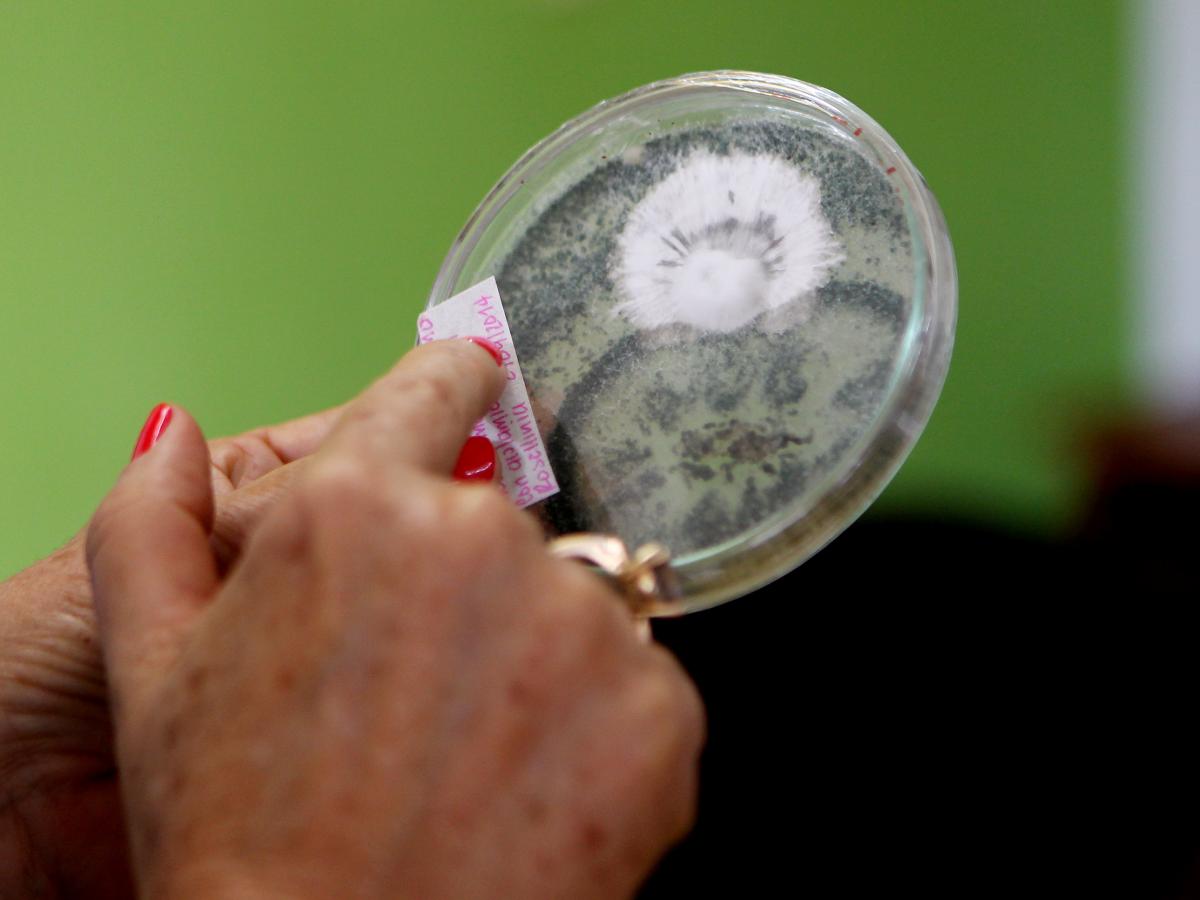

Métodos biológicos y naturales para el control de plagas Parte 02
00:00
/


00:00
Miércoles, Febrero 20, 2019 - 10:12
Métodos biológicos y naturales para el control de plagas Parte 02
Productores del campo, la subdirección agrícola del Instituto Colombiano Agropecuario, ICA y el Phd en Entomología de Nicaragua, Edgardo Jiménez Martínez, hablaron en el campo en la radio sobre los métodos que se pueden usar en el campo para el control de plagas.
Escúchelos de lunes a viernes de 4 a 6 de la mañana.
Emisión 19 de febrero de 2019
Más Episodios

Son muchas las mujeres de Buenaventura que se dedican a la extracción de la piangua de las raíces de los manglares; una actividad ancestral que forma parte de la economía de la región. Solo el pacífico colombiano conserva el 70 por ciento de los manglares del país y también es la única posibilidad de ingresos de un grupo de mujeres que sustenta su vida día a día sacando las pianguas, un molusco rico en hierro, calcio y proteínas solo por mencionar algunos beneficios nutritivos.Rosa Delia Angulo hace parte de la Federación de Pescadores Artesanales del Pacífico y conversó en el Campo en la Radio TV sobre su trabajo, la importancia de la piangua en su familia, sobre cómo son las faenas diarias y su trabajo con la asociación. También expresó su preocupación sobre la falta de garantías para el desarrollo de su trabajo por las limitaciones que existen sobre la pesca incidental y las enfermedades vaginales que ellas enfrentan por mantener tanto tiempo con el lodo además, dejó en el aire la gran preocupación por que las nuevas generaciones ya no están interesadas en esta labor que es poco rentable porque el kilo de piangua solo pagan 30 mil pesos y extraerlas es una faena de varios días con exposiciones a su salud.Escúchelos de lunes a viernes de 4 a 6 de la mañana.Emisión 06 de diciembre del 2024.

A propósito del fin de semana en el que se celebra el Amor y la Amistad en Colombia, quisimos conocer cuáles son las historias de amor de nuestros oyentes. Y es que esta celebración es un buen momento para reconocer la importancia del amor en nuestras vidas y recordar que se puede experimentar de diversas maneras, no solamente a través de relaciones amorosas sino también por medio de relaciones de amistad.Escúchelos de lunes a viernes de 4 a 6 de la mañana.Emisión 20 de septiembre del 2024.

Cada 19 de septiembre se celebra el Día Internacional de Concienciación sobre la Mordedura de Serpiente con el objetivo de crear conciencia sobre la incidencia mundial de las lesiones por mordedura de serpiente. Además también se quiere sensibilizar a la población sobre cómo prevenir las mordeduras de serpientes.En Colombia no debemos ser ajenos a que esto podría suceder en el momento menos esperado. Para estar preparados ante esta eventualidad, escuchamos los conceptos de Teddy Angarita Sierra (Herpetólogo Profesor de la Universidad Nacional) y del doctor Francisco Ruiz (herpetólogo Coordinador del Serpentario del INS).Escúchelos de lunes a viernes de 4 a 6 de la mañana.Emisión 19 de septiembre del 2024.

CampeSENA es una estrategia, precisamente, del SENA para promover el reconocimiento de la labor del campesinado colombiano, fortalecer su economía y facilitar el acceso de esta población a los diferentes programas y servicios de la institución con justicia social, ambiental y económica.Con esta estrategia, se busca fortalecer las capacidades, conocimientos y habilidades de la población campesina, y abrirle la puerta a nuevas opciones que le permitan incrementar sus ingresos y mejorar su calidad de vida. Para conocer más sobre esta iniciativa, nos acompañó Luis Alejandro Jiménez (Director del Sistema Nacional de Formación para el trabajo del SENA). Además, escuchamos la experiencia de Jhon Jairo Acosta (Instructor campesino) y quien ha vivido de primera mano esta experiencia.Escúchelos de lunes a viernes de 4 a 6 de la mañana.Emisión 18 de septiembre del 2024.

Amada por muchos y odiada por otros, la cebolla es uno de los ingredientes imprescindibles en el país y un alimento básico en la mayoría de los hogares colombianos. Existen muchos tipos de cebolla, pero todas tienen algo en común: su principal ventaja es que le dan sabor a cualquier plato, en cualquiera de sus versiones, y tiene diversos usos.Se puede utilizar en diversas preparaciones y se consigue de todo tipo, empezando por la larga y la cabezona, las cuales son las más conocidas. Para conocer más sobre este cultivo tan importante en el campo colombiano, hablamos con Azucena Bautista Sandoval (Cultivadora de cebolla larga y cabezona) y con Javier Fernando Rodríguez (Ingeniero agrónomo).Escúchelos de lunes a viernes de 4 a 6 de la mañana.Emisión 17 de septiembre del 2024.

El campesino colombiano se caracteriza por su emprendimiento y buscar soluciones ante cualquier solución. Esto queda más que demostrado cuando se da un vistazo a las iniciativas y todo lo que buscan hacer para salir adelante.Esto sucede en varias partes del país, por lo que esta vez en particular, conectamos con una emisora regional para conocer los que hay allá. Desde el Tambo, Cauca, hablamos con Leidy Esperanza Tobar (emprendedora, artesana y docente de ARTE DADIMM) y con Ana Melina Palechor (Líder comunitaria y emprendedora) para conocer su experiencia y el trabajo que realizan día tras día.Escúchelos de lunes a viernes de 4 a 6 de la mañana.Emisión 16 de septiembre del 2024.

Muchas veces, la comida es una buena manera de llegar al corazón de una persona. Ya sea porque ciertos sabores nos recuerdan a la infancia o simplemente porque nos transportan a lugares que nos sacan de la rutina y nos tranquilizan. Tanto así, que incluso la gastronomía puede llegar a ser utilizada para “conquistar” a una persona y despertar sentimientos en ella.Existen muchas maneras de lograr lo anterior, por lo cual es importante adentrarse en toda la variedad de la cocina colombiana. Para lograr esto, nos conectamos con el chef Leonel Jaramillo (experto en platos típicos y gastronomía) y así conocer más sobre los diversos sabores que representan a nuestro país.Escúchelos de lunes a viernes de 4 a 6 de la mañana.Emisión 13 de septiembre del 2024.

La aparición, y auge, de nuevas tecnologías se supone que deberían facilitar las labores de todos los seres humanos y el agro no es la excepción. Y es que cada vez aparecen más y más métodos que facilitan tareas como la identificación y reconocimiento de linderos, trabajo de campo, realizar el análisis y diagnóstico, de cómo se llevan las tareas diarias hasta el momento y como mejorarlas y muchas otras técnicas más.Implementar lo anterior es importante para facilitar una labor que es fundamental para todos los colombianos como son las que se realizan en el campo colombiano. Por eso y para entender cuál es el alcance de estas herramientas, conversamos con José Omar Sánchez (zootecnista y especialista en mediciones y evaluaciones agrotécnicas).Escúchelos de lunes a viernes de 4 a 6 de la mañana.Emisión 12 de septiembre del 2024.